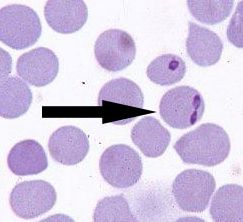

大型ピロプラズマ(Babesia ovata)、本種は、B.bigemingに酷似していて、本邦で従来、牛の大型ピロプラズマと呼ばれていたものです。
洋ナシ状の虫体は、2.5~3.8 x 1.1~2.3(平均3.16 x 1.67)㎛でB.bigeminaに比べてずんぐりしています。本種は本邦の牛にだけ認められ、沖縄を除く日本各地に分布します。
媒介ダニはフタトゲチマダニ(Haemaphysalis longicornis)です。
≪牛≫大型ピロプラズマ ~ 本種は本邦の牛にだけ認められ、沖縄を除く日本各地に分布
 胞子虫類
胞子虫類